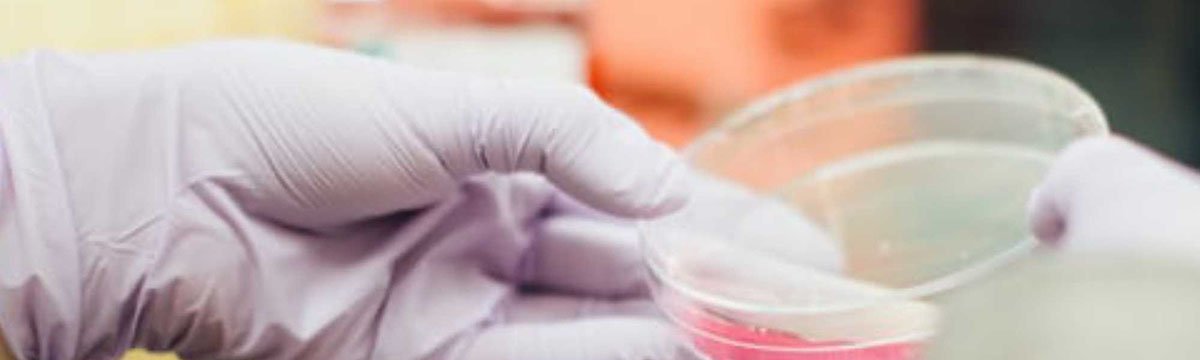
ΛΥΣΕΙΣ SENSITECH

Διαχείριση Κρύας Αλυσίδας: Ένα Κρίσιμο Σημείο για τα Ευαίσθητα στη Θερμοκρασία Φάρμακα Κλινικών Δοκιμών
Life Sciences
Η επιβάρυνση εμφάνισης ασθενειών, η αύξηση του γηράσκοντος πληθυσμού και η μείωση του αγωγού προϊόντων των παλαιοτέρων συχνά συνταγογραφούμενων φαρμάκων, ωθούν τις φαρμακευτικά και βιοτεχνολογικές βιομηχανίες να διαθέσουν νέες χημικές ουσίες και να εμπορεύονται νέα φάρμακα με αυξανόμενο ρυθμό.
Αυτά τα προϊόντα δεν μπορούν να διατεθούν στην αγορά, χωρίς τις κατάλληλες κλινικές δοκιμές, οι οποίες διεξάγονται σε παγκόσμια κλίμακα, με διαφορετικούς πληθυσμούς και σε ορισμένες περιπτώσεις σε τοποθεσίες με λιγότερο από βέλτιστες ή αναπτυσσόμενες υποδομές logistics.
Στην κλινική αλυσίδα εφοδιασμού, κάθε μεμονωμένο τμήματα είναι κρίσιμο για την ακεραιότητα, την αποτελεσματικότητα και την ασφάλεια των υπό δοκιμή φαρμάκων, από τα Δραστικές Φαρμακευτικές Ουσίες (API) και την παρασκευή φαρμάκων έως και την παράδοση στον ασθενή. Αυτό ισχύει ιδιαίτερα για τα ευαίσθητα στη θερμοκρασία και στο χρόνο φάρμακα που χρησιμοποιούνται στις κλινικές δοκιμές.
Χωρίς την απαραίτητη συμμόρφωση κατά την παραγωγή, αποθήκευση και διανομή αυτών των φαρμάκων, οι ασθενείς κινδυνεύουν να πάρουν ανασφαλή ή αλλοιωμένα προϊόντα. Επιπλέον, οι κλινικές δοκιμές θα μπορούσαν να καθυστερήσουν, να καταλήξουν σε ασυνεπή αποτελέσματα ή ακόμη και να αποτύχουν
Σε αυτό το σημείο είναι που η διαχείριση της κρύας αλυσίδας αναλαμβάνει τον ρόλο της, καθώς απαιτείται ο κατάλληλος έλεγχος, ώστε να εξασφαλισθούν τα ισχύοντα πρότυπα άριστης ποιότητας. Χωρίς αυτά, ο αντίκτυπος των παραβιάσεων ορίων θερμοκρασίας, θα είναι καταστροφικός για την ακεραιότητα των ευαίσθητων στη θερμοκρασία προϊόντων.
Μάθετε περισσότερα για το πώς οι υπηρεσίες Sensitech® ColdStream® Quality and Compliance και τα προϊόντα αυτής, προσφέρουν λύσεις για τις προκλήσεις των ρυθμιστικών κανονισμών και της εφοδιαστικής αλυσίδας.
Γιατί η ορθή διαχείριση της κρύας αλυσίδας είναι ζωτικής σημασίας
Η βέλτιστη συντήρηση της ψυχρής αλυσίδας καθίσταται ολοένα και πιο σημαντική καθώς οι εταιρείες αντιμετωπίζουν συνεχώς αυξανόμενες ρυθμιστικές ανησυχίες, εκτεταμένη ανάπτυξη βιολογικών και εμβολίων και αυξανόμενο κόστος εφοδιασμού. Στόχος σε κάθε μία από αυτές τις τάσεις είναι να διασφαλιστεί το μέγιστο για την ασφάλεια των ασθενών.
Στην μελέτη που έγινε από SCORR Marketing and Applied Clinical Trials, οι ερωτηθέντες από διάφορους τύπους εταιρειών που συμμετείχαν σε κλινικές δοκιμές παρείχαν κάποιες πληροφορίες για τη διαχείριση της ψυχρής αλυσίδας. Ακολουθούν μερικές επισημάνσεις:
- Σχεδόν οι μισοί (49%) των ερωτηθέντων επισήμαναν ότι η αξιοπιστία είναι η κορυφαία επιρροή στις κλινικές αποφάσεις για την ψυχρή αλυσίδα εφοδιασμού.
- Πάνω από το 65% δήλωσαν ότι οι τάσεις των κανονισμών έχουν κάποιο έως πολύ σημαντικό αντίκτυπο στη διανομή ψυχρής αλυσίδας. Επιπλέον, για πάνω από 60% των ερωτηθέντων, ανέφεραν ότι η ανάπτυξη των βιολογικών προϊόντων και των εμβολίων είναι καθοριστικής σημασίας. Πάνω από το 50% ανέφερε το κόστος της εφοδιαστικής αλυσίδας ως σημαντικό παράγοντα.
- Για καλύτερη διαχείριση, η παρακολούθηση θερμοκρασίας είναι η κορυφαία λύση τεχνολογίας, βρίσκει το 63% των ερωτηθέντων να βασίζονται σε αυτή.
Οι βέλτιστες πρακτικές και τα πρωτόκολλα είναι το κλειδί
Για να ανταποκριθούν οι εταιρείες στις προκλήσεις της διαχείρισης της κρύας αλυσίδας, αναζητούν τεκμηριωμένα πρωτόκολλα και βέλτιστες πρακτικές που συμμορφώνονται με τις Ορθές Πρακτικές Διαχείρισης της Ψυχρής Αλυσίδας (GCCMP). Έτσι υποστηρίζουν τη συμμόρφωση προς τους κανονισμούς της βιομηχανίας και της κυβέρνησης. Αυτές οι πρακτικές είναι ιδιαίτερα σημαντικές για τη διαχείριση της κρύας αλυσίδας για φάρμακα ευαίσθητα στη θερμοκρασία και των κλινικών δοκιμών.
Για την εξασφάλιση της σωστής διαχείρισης της θερμοκρασίας σε δοκιμαστικές θεραπείες, συνιστώμενη πηγή είναι η του Μαρτίου 2015 οδηγία, EU Guidelines for Good Manufacturing Practice for Medicinal Products for Human and Veterinary Use (Annex 15: Qualification and Validation). Το έγγραφο αυτό περιγράφει τις αρχές πιστοποίησης και επικύρωσης, οι οποίες ισχύουν για τις εγκαταστάσεις, τον εξοπλισμό, τα βοηθητικά προγράμματα και τις διαδικασίες που χρησιμοποιούνται για την παρασκευή φαρμακευτικών προϊόντων. Μπορεί επίσης, να χρησιμοποιηθεί ως συμπληρωματική προαιρετική καθοδήγηση για δραστικές ουσίες.
Ασκείται αυξημένη κανονιστική πίεση τόσο για τη σύναψη τεχνικών συμφωνιών ποιότητας με εταίρους της εφοδιαστικής αλυσίδας, όσο και για τον έλεγχο προμηθευτών με στόχο τη συνεχή βελτίωση. Στη μελέτη που αναφέρθηκε παραπάνω, το 57% των εταιρειών που συμμετείχαν στην έρευνα ανέθεσαν σε εξωτερικούς συνεργάτες τη διαχείριση της ψυχρής αλυσίδας εφοδιασμού. Σε αυτές τις περιπτώσεις ενδέχεται να απαιτείται εκπαίδευση για βέλτιστες πρακτικές για την κατάλληλη αποθήκευση, χειρισμό και διανομή.
Οι κατευθυντήριες οδηγίες της ΕΕ περιγράφουν μια ποιοτική προσέγγιση διαχείρισης κινδύνων και καθορισμένες διαδικασίες που πρέπει να εφαρμόζονται καθ ‘όλη τη διάρκεια του κύκλου ζωής ενός φαρμάκου. Επιπλέον, παρέχει πληροφορίες σχετικά με το τι πρέπει να παρέχει ένα σύστημα διαχείρισης κινδύνων ποιότητας, όπως αιτιολόγηση του πεδίου και του εύρους των προσόντων και της επικύρωσης που καλύπτει τις εγκαταστάσεις, τον εξοπλισμό, τα βοηθητικά προγράμματα και τις διαδικασίες.
Οι μεταφορές αποτελούν επίσης βασικό τομέα που καλύπτεται από τις κατευθυντήριες γραμμές της ΕΕ. Ακολουθούν ορισμένες λεπτομέρειες:
- Τα τελικά φαρμακευτικά προϊόντα, τα ερευνητικά φάρμακα, το χύμα προϊόν και τα δείγματα πρέπει να μεταφέρονται από τις εγκαταστάσεις παραγωγής σύμφωνα με τους όρους που καθορίζονται στην άδεια κυκλοφορίας, την εγκεκριμένη ετικέτα, το αρχείο προδιαγραφών προϊόντος ή όπως ορίζεται από τον κατασκευαστή.
- Αναγνωρίζεται ότι η πιστοποίηση της μεταφοράς μπορεί να είναι δύσκολη λόγω των σχετικών μεταβλητών παραγόντων. Ωστόσο, οι διαδρομές μεταφοράς πρέπει να καθοριστούν με σαφήνεια. Εποχικές και άλλες παραλλαγές θα πρέπει επίσης να λαμβάνονται υπόψη κατά την πιστοποίηση της μεταφοράς.
- Θα πρέπει να διενεργηθεί εκτίμηση κινδύνου για να ληφθεί υπόψη ο αντίκτυπος των μεταβλητών στη διαδικασία μεταφοράς εκτός από εκείνες τις συνθήκες που ελέγχονται ή παρακολουθούνται συνεχώς. Αυτό περιλαμβάνει καθυστερήσεις κατά τη μεταφορά, αστοχία συσκευών παρακολούθησης, ευαισθησία προϊόντος και άλλους σχετικούς παράγοντες.
- Λόγω των αναμενόμενων μεταβλητών συνθηκών κατά τη μεταφορά, πρέπει να εκτελείται συνεχής παρακολούθηση και καταγραφή τυχόν κρίσιμων περιβαλλοντικών συνθηκών στις οποίες ενδέχεται να υποβληθεί το προϊόν.
H Συμβολή της Sensitech
Η Sensitech Professional Services θα συντάξει μια αξιολόγηση της ευαίσθητης στη θερμοκρασία αλυσίδας εφοδιασμού / temperature-sensitive supply chain assessment και θα αξιολογήσει, θα τεκμηριώσει τις εσωτερικές και εξωτερικές πρακτικές όπως ορίζονται από τις Οδηγίες της ΕΕ. Κάθε αξιολόγηση προσαρμόζεται ώστε να ανταποκρίνεται στις ανάγκες και τους αντικειμενικούς στόχους κάθε πελάτη, με σκοπό τον εντοπισμό των κενών θερμικής συμμόρφωσης και ευκαιριών βελτίωσης. Για παράδειγμα, μια αξιολόγηση μπορεί να περιλαμβάνει τη συνολική αξιολόγηση των παγκόσμιων αλυσίδων εφοδιασμού σε διαφορετικές εποχές, ή θα μπορούσε να προσαρμοστεί στην αξιολόγηση μιας συγκεκριμένης εμπορικής λωρίδας, προϊόντος ή άλλης μεταβλητής.
Ένα άλλο βασικό βήμα που απαιτείται από τις ρυθμιστικές υπηρεσίες είναι η ορθή τήρηση ηλεκτρονικών αρχείων. Αυτό σχετίζεται με το γεγονός ότι η πλειονότητα των ατόμων που ρωτήθηκαν παραπάνω χρησιμοποιούν τεχνολογία παρακολούθησης θερμοκρασίας. Σε αυτό περιλαμβάνεται συνήθως ένα ασφαλές και ολοκληρωμένο σύστημα διαχείρισης δεδομένων για προβολή, αποθήκευση, ανάκτηση και ανάλυση δεδομένων χρόνου και θερμοκρασίας για ευαίσθητες θερμοκρασίες αποστολές. Το σύστημα διαχείρισης δεδομένων πρέπει να σχεδιαστεί και να κατασκευαστεί ώστε να συμμορφώνεται με τις οδηγίες FDA 21 CFR Μέρος 11 και το Παράρτημα 11 ΕΚ (Διαχείριση δεδομένων). Η χρήση αυτής της τεχνολογίας αποδεικνύει τον έλεγχο και παρέχει στις εταιρείες ειδοποιήσεις που ενδέχεται να ξεκινήσουν έρευνες, οι οποίες πρέπει επίσης να τεκμηριωθούν.
Πηγή: Sensitech Inc., USA
